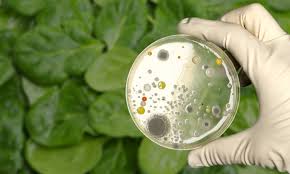

728x90
SMALL

블로그 운영자 ‘상상드림’구독자님을 위해, “생으로 먹으면 건강하다”는 생각에 경종을 울릴 만한 10가지 채소에 대해 유머 한 스푼 섞어 정리해봤습니다. 단, 모든 생채소가 위험한 건 아니고 특정한 경우에 조리해야 하는 것들이니 참고용으로 읽어주세요!
들어가며
우리는 “생식! 신선함의 상징!”이라며 생채소를 즐기곤 하지만, 사실 특정 채소는 생으로 먹으면 독소·소화불량·기생충 위험 등을 안고 있습니다.
식품안전 전문 자료에서도 “생 과일·채소도 병원균의 온상이 될 수 있다”고 경고합니다. FoodSafety.gov+1
따라서 다음 항목들을 보며 “이 녀석, 조리해야 하나?”라는 생각 한 번쯤 해보시면 좋습니다.
생으로 먹으면 위험한 채소 10가지
※ 각 채소별로 ‘어떤 위험이 있다’, ‘어떻게 조리하는 게 좋다’ 등 두 가지 포인트로 정리했습니다.
1. 감자 (Potato)



- 위험 요인 : 생감자에는 독성 물질인 글리코알칼로이드(솔라닌·차코닌)가 함유되어 있습니다. 특히 초록빛이 도는 감자나 싹이 난 감자는 농도가 높아져서 위장 장애, 두통, 심한 경우 신경계 증상을 유발할 수 있습니다. 위키백과+1
- 조리 팁 : 반드시 껍질을 벗기고, 싹이나 초록 부분은 제거한 뒤 삶거나 구워 먹는 것이 안전합니다.
- 블로그 팁 : “감자 샐러드? 살짝 데치고 식히자!” 같은 제목으로 글을 시작해보시면 클릭률이 올라갑니다 😉
2. 가지 (Eggplant)



- 위험 요인 : 가지 역시 밤나무과 채소로 솔라닌 유사 독소가 존재하며, 생으로 먹을 경우 소화가 안 되거나 위장에 부담이 있을 수 있습니다. Eat This Not That+1
- 조리 팁 : 기름에 볶거나 구워서 수분을 날리고, 익혀서 먹는 것이 좋습니다.
- 블로그 연출 팁 : “생가지는 NO! 구워야 맛과 안전을 잡는다” 라는 키워드로 제목 구성.
3. 양배추‐브뤼셀스프라우트 등 십자화과 채소 (Cabbage, Brussels sprouts, Broccoli 등)

- 위험 요인 : 생으로 섭취하면 잦은 경우 가스·팽만감이 올 수 있고, 갑상선 기능에 영향을 줄 수 있는 물질도 포함되어 있다는 지적이 있습니다. AARP+1
- 조리 팁 : 살짝 데치거나 증기로 익혀 먹으면 소화도 잘 되고 영양 흡수도 도와줍니다.
- 블로그 활용 팁 : “십자화과 채소, 초고속으로 데치면…?” 스타일의 영상이나 카드뉴스로 제작하면 SNS 공유도 잘 되겠죠!
4. 시금치 (Spinach)

- 위험 요인 : 시금치는 식중독균(예: E. coli) 감염의 위험이 있을 뿐 아니라, 옥살산 등의 성분으로 인해 칼슘 흡수를 저해할 수 있다는 언급도 있습니다. Healthshots+1
- 조리 팁 : 살짝 데쳐서 수분을 빼고, 올리브유·마늘과 함께 볶으면 맛도 영양도 챙길 수 있습니다.
- 유머 삽입 팁 : “판타지 드래곤도 시금치 앞에선 방귀 뀔 수 있다” 같은 유머 문구로 시작해보는 건 어떨까요?
5. 피망/파프리카 (Capsicum / Bell Pepper)



- 위험 요인 : 일부 전문가들은 피망의 씨앗·내피에 기생충(예: 촌충)의 알이 남아 있을 수 있다고 경고합니다. The Times of India
- 조리 팁 : 생으로 먹더라도 반드시 씨와 껍질 부분을 잘 제거하고 살짝 데치거나 껍질을 불맛나게 구워 먹으면 맛도 업!
- 콘텐츠 아이디어 : “피망이 샐러드에서 탈출하는 이유”라는 제목으로 독자의 흥미 유발 가능.
6. 고구마 및 일부 뿌리채소 (Sweet Potato & Root Vegetables)



- 위험 요인 : 생 고구마·뿌리채소는 딱딱하고 섬유질이 많아 소화가 잘 안될 수 있으며, 일부에는 산성화 유발 성분이나 항영양소가 포함되어 있다는 언급이 있습니다. AARP+1
- 조리 팁 : 삶거나 찌거나 구워서 먹는 것이 베스트이며, 특히 아이들이 먹을 경우 익혀서 식감 부드럽게 해주는 게 좋아요.
7. 감자콩류-강낭콩류 생식 (Raw Beans / Kidney Beans)



- 위험 요인 : 생 또는 미숙 익힌 강낭콩류에는 렉틴이라는 독성이 있어 구토·설사·복통 등을 유발할 수 있습니다. Eat This Not That+1
- 조리 팁 : 반드시 물에 충분히 담가 불린 후 끓는 물에 익혀서 렉틴이 제거되도록 해야 합니다.
- 블로그 이야기거리 : “콩세리머니 – 물에 담그고 30분간! 그래야 안전하다” 같은 제목으로 재미를 더해보세요.
8. 콜로케이사 잎(까마리) 등 옥살레이트 다량 뿌리채소 (Colocasia leaves)



6
- 위험 요인 : 인도 등 일부 지역에서 언급된 채소로, 생으로 먹을 경우 옥살레이트(칼슘 흡수를 방해하고 신장결석 위험을 높이는 물질)가 많을 수 있다고 나옵니다. Healthshots
- 조리 팁 : 삶아서 물을 버리거나 데친 후 조리하는 방법이 권장됩니다.
- 블로그 활용 팁 : “지역 채소 탐구 – 옥살레이트 함정에 빠지지 않기” 같이 전문성 강조.
9. 기타 뿌리·잎채소의 항영양소 문제 (예: 루바브 잎, 일부 야생채)



- 위험 요인 : 루바브 잎에는 옥살산염이 많아 생으로 먹으면 구토·경련을 유발할 수 있습니다. Eat This Not That
- 조리 팁 : 잎을 제거하고 줄기만 사용하거나, 반드시 익혀 먹는 것이 안전합니다.
- 블로그 아이디어 : “잎이 초록이라 곧바로 먹으면 아찔하다”라는 경고성 헤드라인도 고려해보세요.
10. 일부 야생 채소 및 버섯류 (Wild Mushrooms, Unknown Greens)



- 위험 요인 : 슈퍼마켓에 파는 종류라면 덜 위험하지만, 야생 버섯이나 이름 모를 잎채소는 생식 시 독버섯 독소 또는 기생충 위험이 있습니다. Eat This Not That+1
- 조리 팁 : 반드시 신뢰 가능한 종류인지 확인하고, 익혀서 먹는 것이 안전합니다.
- 블로그 스타일 제안 : “숲에서 캔 채소 한입? 생으로는 ‘에어 ~ 위험’” 같은 유머러스한 접근을 추천!
마치며
- 생채소가 모두 ‘무조건 건강하다’는 공식은 성립하지 않습니다. 일부는 조리해야 독소가 제거되고 영양흡수도 좋아집니다.
- 물론 대부분의 채소는 생으로 먹어도 큰 문제 없고 오히려 좋지만, 위에서 언급한 특정 종류는 주의가 필요합니다.
- 독자에게는 “생식도 좋지만, 어떤 채소는 익혀 먹어야 한다”는 인식을 심어주면 신뢰도 ↑입니다.
- 블로그 운영자님 스타일대로라면, 각 채소마다 “생 vs 익혔을 때 비교 이미지” + “조리 꿀팁 한 줄” + “미니 유머” 삽입하면 독자반응이 좋겠습니다.
728x90
'음식,맛집' 카테고리의 다른 글
| ▶ 카사노바가 사랑한 음식 '굴' 많이 먹으면 정력도 세질까 (0) | 2025.11.07 |
|---|---|
| ♧ 소노캄 경주, 영부인 차담회 메뉴 정식 출시 (1) | 2025.11.06 |
| 🌊 "동해안 참다랑어 해체쇼"-'부산 국제수산엑스포' (1) | 2025.11.05 |
| 🍲 “미꾸리를 아시나요”…제대로 먹는 추어탕의 정석 (1) | 2025.11.05 |
| 👋 제철의 특별함 ‘제철코어’…조개류 안전하게 즐기는 법 (0) | 2025.11.02 |